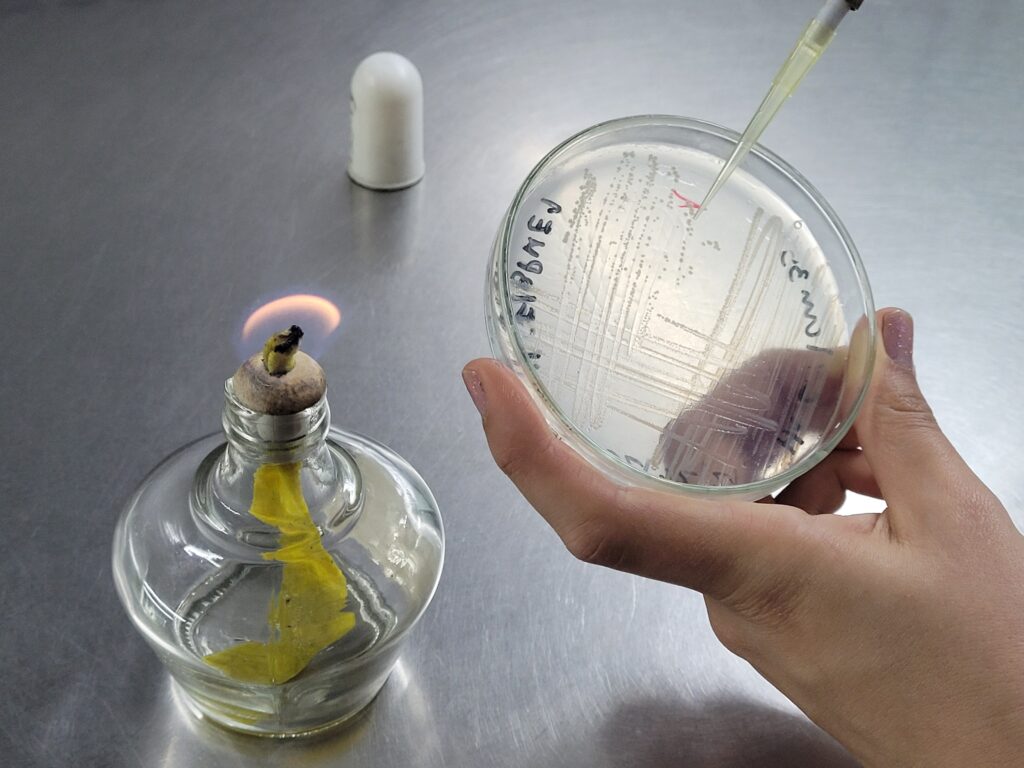

De la basura encontrada en las costas bonaerense casi el 85% son plásticos. Eso en las playas y a simple vista, pero en el fondo marino el problema es aún más grave e invisible: los microplásticos. La alternativa a esta problemática ambiental surgió por parte de un grupo de científicas de Mar del Plata que aislaron una bacteria hallada en el mar y posee dos cualidades: se alimenta de desechos de hidrocarburos y los transforma en bioplásticos. Esto es: se deshace de un pasivo ambiental para producir un producto biodegradable, un sustituto al plástico derivado del petróleo.
“Los plásticos están siendo un problema porque a lo largo de los años se fueron acumulando y tardan muchísimo tiempo en degradarse, entre 400 y 500 años”, explicó Karina Herrera Seitz, investigadora del CONICET en el Instituto de Investigaciones Biológicas (IIB-CONICET, UNMdP, asociado a la CIC).
“Esto es porque los plásticos generados a partir del petróleo -que son la mayoría de los que usamos- son muy difícilmente atacables para los microorganismos. Eso hace que persistan mucho tiempo en el ambiente con las consecuencias que estamos viendo ahora: los mares están llenos de plásticos, se van rompiendo sin degradarse y se transforman en microplásticos”.
A raíz de esto y en base a un largo trabajo de investigación, este grupo de científicas marplatenses se enfocaron en la producción de bioplásticos a partir de otras fuentes: “en este caso, a partir de microorganismos que tienen una característica fundamental: el bioplástico que producen es fácilmente degradable. Esto quiere decir que en uno o dos años desaparecen del ambiente”, aseguró Herrera Seitz.
Las científicas, junto a diferentes grupos de investigación, se encuentran evaluando las posibles aplicaciones de una bacteria asombrosa. Por su relevancia, la iniciativa fue seleccionada en la convocatoria “Ideas-Proyectos” de la Comisión de Investigaciones Científicas de la provincia de Buenos Aires.
Una bacteria titánica
“Aislamos un ‘bicho’ de agua de mar en la zona del puerto de Mar del Plata, estábamos interesados en estudiar la quimiotaxis de las bacterias. Esta es como el ‘olfato’ de las bacterias. A partir de esta pueden ‘oler’ la comida en el medioambiente en donde viven y desplazarse hacia ella”, contó Herrera Seitz.

“Trabajábamos con eso y nos topamos con una bacteria (Halomonas titanicae, cepa KHS3)”. Esta bacteria es muy parecida en su secuencia genómica a la bacteria Halomonas titanicae descubierta en los restos del Titanic en el 2010. Pero esto es solo una curiosidad, lo que llamó la atención de las investigadoras es que esta bacteria podría tener la potencialidad de acumular bioplásticos.
Herrera Seitz explicó que “los bioplásticos son cadenas largas de moléculas de carbono. Específicamente los monómeros de los bioplásticos suelen ser 3-hidroxibutirato (una molécula de cuatro carbonos) de esa molécula se hace un biopolímero que es sintetizado por microorganismos”.
“Y así como los microorganismos sintetizan este biopolímero también lo pueden degradar en un breve período de tiempo: entre uno o dos años”, puntualizó Herrera Seitz.
Esta bacteria, por otro lado, tiene la capacidad de alimentarse de hidrocarburos. “Sintetiza bioplásticos a partir de otras fuentes de carbono como glicerol (residuo de la producción de biodiesel) o glucosa; también podría ‘comer’ fenantreno (este es un hidrocarburo aromático que persisten mucho en el ambiente); o naftaleno u otros hidrocarburos aromáticos. Y en condiciones adecuadas los puede convertir en bioplásticos”, detalló la experta.
Y aseguró que: “Idealmente se busca un residuo industrial que la bacteria ‘coma’ para generar un bioplástico”. Dicho de otro modo: Halomonas titanicae puede deshacerse de un pasivo ambiental creando un bioplástico que será degradable.
Una de las ventajas es que esta bacteria aislada del agua de mar resiste altas concentraciones de sal. El agua de mar tiene un 3% de sales y esta bacteria puede aguantar entre un 6 y 8%. ¿Por qué esto es importante?
“Esto es interesante por dos cuestiones: si queremos tratar efluentes de distintas industrias, estos suelen tener altos contenidos de sales. Por otro lado, si pensamos la producción de bioplásticos en reactores y le subimos las sales a un medio de cultivo es menos probable que se contamine, esto quiere decir que se pueden tener menos condiciones de esterilidad y por lo tanto es menos costosa la producción de bioplásticos”, indicó Herrera Seitz. El desafío, en definitiva, está en los costos.
La experta afirmó que “el gran problema por el cual los bioplásticos no reemplazan a los plásticos derivados del petróleo son los costos de producción”.
“La producción de bioplásticos requiere hacer crecer un bichito (una bacteria) en unos tanques enormes, se les da de comer un sustrato que luego lo convertirá en bioplástico; entonces, el cultivo y las fuentes de carbono que se le da de comer elevan los costos de producción”.
“Desde hace por lo menos 20 años se conoce en el mundo, pero hasta ahora no se pudo equiparar los costos a las de producción de bioplásticos con los plásticos derivados del petróleo, y este es uno de los grandes desafíos”, indicó.
Bioplásticos: ¿Cómo es el proceso de producción?
La producción requiere de reactores de distintos volúmenes. Se inicia haciendo un cultivo pequeño en laboratorio. Luego se inocula un reactor de 20 litros, por ejemplo, y se va escalando. En estos reactores se alojan las bacterias con nutrientes para que puedan prosperar: crecer, reproducirse y acumular bioplástico.
“Para que haya producción de bioplástico tienen que estar en una situación de desbalance”, explicó la especialista. ¿Cómo es ese desbalance? Con mucha fuente de carbono y otro nutriente limitado como pueden ser fósforo o nitrógeno.
“De esta manera la bacteria crece a partir de la fuente de carbono y la acumula dentro de su cuerpo en forma de gránulos de polímero”, graficó Herrera Seitz. Luego se cosechan los biopolímeros y se convierten en pellets, materia prima en la fabricación de los artículos de bioplástico”.
“El polímero más común generado por las bacterias se llama ácido poli(R)-(3-hidroxibutírico) PHB, este bioplástico es un poco quebradizo. Si se buscan características más flexibles del bioplástico se puede utilizar una variedad de bacterias que sintetizan otro tipo de polímero, modificar la alimentación de las bacterias o mezclar el biopolímero con otros compuestos”, explicó.



Una bacteria entre otras
Pero antes de llegar a la producción industrial, se buscan alternativas a desafíos inmediatos y cercanos al laboratorio. Es así que las investigadoras del IIB comenzaron a colaborar con otros grupos con el fin de estudiar la potencialidad que tiene Halomonas titanicae. De esa manera se relacionaron con un grupo de ingeniería bioquímica de la Facultad de Ingeniería de la UNMdP.
“Ellos trabajan en degradación y tienen acceso a un consorcio microbiano, un grupo de microorganismos variables que degradan hidrocarburos provenientes de las sentinas”, explicó Herrera Seitz. Las sentinas son reservorios que tienen todos los barcos. Allí se alojan los residuos que se generan: lubricantes, combustible, entre otros hidrocarburos. La sentina se descarga del barco y se procesa.
“Se nos ocurrió hacer una colaboración para ver si este consorcio que degradan hidrocarburos además puede transformar en bioplásticos o en algún tipo de biopolímero. Esto es todo un desafío porque hay poca experiencia en relacionadas a un consorcio de bacterias que generen biopolímeros”, aclaró la investigadora.
Aplicación en biomedicina
Por otro lado, las científicas se encuentran colaborando con un grupo de investigadoras/es del Instituto de Investigaciones en Ciencia y Tecnología de Materiales (INTEMA) que trabajan en biopolímeros con utilidades médicas.
“Nosotros aportamos el biopolímero generado por nuestra bacteria hallada en el puerto para producir nanopartículas de ácido poli(R)-(3-hidroxibutírico) para que sirvan como vehículo de un antiparasitario”, contó Herrera Seitz.
En concreto, estas nanopartículas son para ser utilizadas en albendazol, un antiparasitario que, entre otras aplicaciones, se utiliza para el tratamiento de hidatidosis, una enfermedad producida por un parásito llamado Echinococcus granulosus y que transmite el perro a través de su materia fecal.
“Es una enfermedad muy persistente sobre todo en áreas rurales del país. El parásito se enquista en los músculos, cerebro o hígado ocasionado problemas de salud en la persona afectada”, explicó la investigadora.
El problema del albendazol es que se debe consumir por tiempos muy prolongados y en dosis muy altas ya que se suministra vía oral y el 50% del antiparasitario se degrada antes de llegar al órgano afectado.
“La posibilidad de meter este antiparasitario en una nanopartícula de ácido poli(R)-(3-hidroxibutírico) permitiría que llegue de forma directa al órgano blanco donde tiene que actuar. Este biopolímero es biodegradable en el cuerpo humano y esta es una ventaja adicional”.
Por Alejandro Armentia